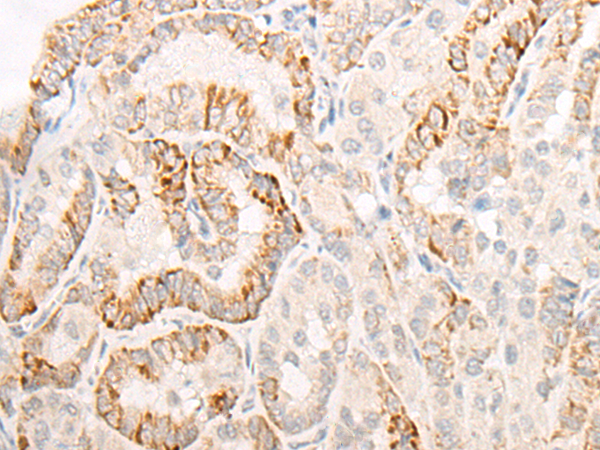

|
Background: |
The pattern of cellular proliferation and differentiation that leads to normal development of embryonic structures often depends upon the localized production of secreted protein signals. Cells surrounding the source of a particular signal respond in a graded manner according to the effective concentration of the signal, and this response produces the pattern of cell types constituting the mature structure. A segment-polarity gene known as dispatched has been identified in Drosophila and its protein product is required for normal Hedgehog (Hh) signaling. This gene is one of two human homologs of Drosophila dispatched. |
|
Applications: |
ELISA, IHC |
|
Name of antibody: |
DISP2 |
|
Immunogen: |
Synthetic peptide of human DISP2 |
|
Full name: |
dispatched RND transporter family member 2 |
|
Synonyms: |
DISPB; HsT16908; LINC00594 |
|
SwissProt: |
A7MBM2 |
|
ELISA Recommended dilution: |
5000-10000 |
|
IHC positive control: |
Human thyroid cancer; |
|
IHC Recommend dilution: |
20-100 |
購(gòu)物車
購(gòu)物車 幫助
幫助
 021-54845833/15800441009
021-54845833/15800441009
